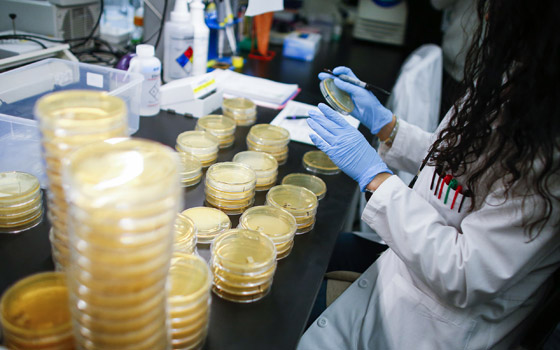
أوروبا تدخل السباق بقوة.. 4 علاجات ولقاحات لكورونا دفعة واحدة صورة رقم 15

على غرار التجارب الأميركية والصينية، دخلت أوروبا بقوة على خط البحث عن لقاح أو علاج لفيروس كورونا المستجد، حيث بدأت تجارب سريرية في 7 دول على الأقل بالقارة لاختبار 4 علاجات محتملة للمرض القاتل. وبدأت تجارب العلاجات الأربعة على 3200 شخص، وتشمل عقاقير "ريمديسيفير"، و"لوبينافير" بخلطه مع "ريتوفانير" على أن يعطى العقار الأخير مع "أنترفيرون بيتا" أو من دونه، فضلا عن "هيدروكسي كلوروكوين، على ما ذكرت هيئة فرنسية للأبحاث الطبية في بيان.
وسيتم اختيار الخاضعين للتجربة من بين أشخاص أدخلوا المستشفى لإصابتهم بفيروس كورونا المستجد في بلجيكا وبريطانيا وفرنسا ولوكسمبورغ وإسبانيا وهولندا وألمانيا، حسبما أكد البيان. وقالت الهيئة الفرنسية أيضا إن تجربة سريرية دولية ستطلق تحت إشراف منظمة الصحة العالمية.

ولا يتوافر حاليا أي لقاح أو علاج ضد فيروس كورونا، الذي تسبب بوفاة أكثر من 14 ألف شخص حتى الآن في العالم. وباشرت الصين أول تجربة سريرية للقاح مضاد لفيروس كورونا المستجد، الأحد. ووزع 108 متطوعا على 3 مجموعات تلقوا الجمعة حقنا أولى، وفقا لصحيفة صينية الصادرة باللغة الإنجـليزية.

وتتراوح أعمار المتطوعين بين 18 و60 عاما، وهم جميعا من مدينة ووهان وسط الصين من حيث انطلق فيروس كورونا المستجد أواخر العام الماضي، قبل أن ينتقل إلى خارج البلد. وسيخضع المتطوعون الصينيون لمتابعة مدة 6 أشهر. وكانت شركات صيدلة عالمية تعهدت الخميس توفير لقاح ضد الفيروس في مهلة تراوح بين 12 و18 شهرا كحد أدنى. وأعلنت روسيا من جهتها أنها باشرت تجربة لقاح على الحيوانات، على أن تصدر نتائجها الأولى في يونيو/حزيران المقبل.